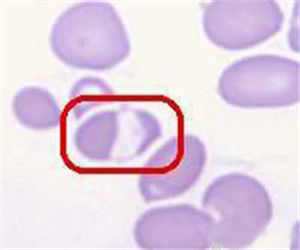
紅細胞固縮

紅細胞固縮
紅細胞中有一側清晰區,而血紅蛋白濃縮偏向另一側,臨床上常見於嬰兒固縮紅細胞增多症。
簡介
尚不十分明了。若將正常紅細胞輸給病兒,正常紅細胞也可變成固縮紅細胞,且壽命與病兒的固縮紅細胞同樣地縮短;提示此種溶血非紅細胞內在缺陷,而是與紅細胞外的某些未明的因素有關。由於SGOT輕度增高病程短暫等可能是一種代謝異常的循環中的氧化問題等。
固縮細胞可見於維生素E缺乏的嬰兒。此外尚可見於嬰兒時期發生的葡萄糖-6磷酸脫氫酶缺陷症、丙酮酸激酶缺陷症或遺傳橢圓形細胞增多症和新生兒肝炎,應與本症鑑別。
臨床表現
大多於出生後數日內起病,主要症狀為高膽紅素血症、貧血和肝脾腫大。貧血逐漸加重,至生後3周時最明顯。早產兒多於生後6~10周發病。
貧血多為輕至中度,網織紅細胞明顯增高,紅細胞多為正細胞正色性,但血片中可見到大量的、可高達50%的染色較深邊緣有棘刺突出的固縮紅細胞,這種細胞在顯微鏡下與棘形和靴刺形細胞不易區別。SGOT輕度升高。
病情多呈自限性經過,於3~6月時溶血自然緩解,固縮紅細胞亦隨之消失。
相關資料
嬰兒固縮細胞增多症(Infantilepyknocytosis)是發生於新生兒或嬰兒期的一種原因不明的非免疫性急性溶血性貧血。其特徵為周圍血中出現形態不規則、染色深、邊緣有棘刺突出的固縮紅細胞。此種細胞約占6%~50%,其多寡大致與溶血的程度成比例。正常新生兒出生後數天內此種細胞占紅細胞的0.3%~1.9%,早產兒生後2~3月內可高達5.6%,於生後3個月迅速減少,兒童與成人其數量不超過0.3%。
膽紅素生成過多新生兒膽紅素是血紅素的分解產物,約80%來源於血紅蛋白,約20%來源於肝臟和其他組織中的血紅素及骨髓中紅細胞前體。新生兒每日生成的膽紅素為8.8mg/kg,成人則為3.8mg/kg,其原因是:胎兒血氧分壓低,紅細胞數量代償性增加,出生趾氧分壓升高,過多的紅細胞破壞;新生兒紅細胞壽命短(早產兒低於70天,足月兒約80天,成人為120天),且血紅蛋白的分解速度是成人的2倍;肝臟和其他組織中的血紅素及骨髓細胞前體較多。
2,聯結的膽紅素量少膽紅素進入血循環,與白蛋白聯結後,運送到肝臟進行代謝。與白蛋白聯結的膽紅素,不能透過細胞膜及血腦屏障引起細胞和腦組織損傷。早產兒胎齡越小,白蛋白含量越低,其聯結膽紅素的量也越少。剛出生的新生兒常有不同程度的酸中毒,也可減少膽紅素與白蛋白聯結。